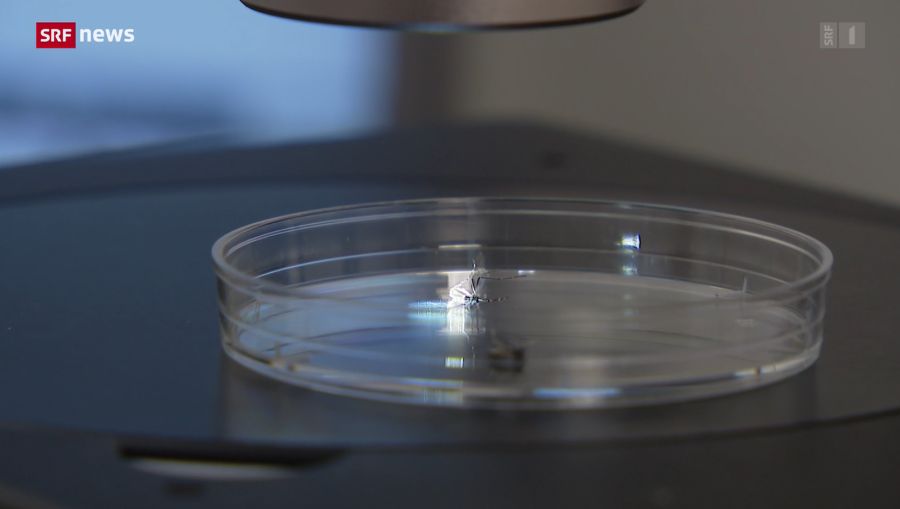
Jetzt wurde das Dengue-Virus lokal bei einer Tigermücke nachgewiesen.

Dengue-Virus in der Schweiz: «Nicht unterschätzen», warnt Experte
Im Basler Kantonslabor wurde in einer Tigermücke das Dengue-Virus entdeckt – erstmals nördlich der Alpen.

Das Wichtigste in Kürze
- Das Dengue-Virus ist in einer Tigermücke in Basel nachgewiesen worden.
- Bisher kamen alle Fälle nur durch Reiserückkehrer – lokale Übertragungen blieben aus.
- Ein Chemiker betont, man dürfe das Risiko einer lokalen Übertragung nicht unterschätzen.
Das Dengue-Virus ist in der Schweiz angekommen – und das mit einer asiatischen Tigermücke. Das ist der erste Dengue-Nachweis in einer Mücke nördlich der Alpen.
In der «Tagesschau» berichtet SRF direkt vom Ort des Geschehens: Das Basler Kantonslabor fängt asiatische Tigermücken und untersucht sie auf Viren.

Nun wurde das Dengue-Virus in einer Tigermücken-Probe festgestellt – vom Team des Basler Kantonslabors um den Kantonschemiker Yves Parrat.
Im Beitrag findet Parrat deutliche Worte: «Das zeigt, dass das Risiko einer lokalen Krankheitsübertragung nicht zu unterschätzen ist.»
«Wir müssen uns auf den Ernstfall vorbereiten»
Wenn auch in geringer Menge, das Risiko sei da. «Wir müssen uns auf den Ernstfall vorbereiten», erklärt Parrat.
Auf der ganzen Welt erkranken jährlich Millionen von Menschen am Dengue-Fieber. Hierzulande blieb man von einer lokalen Infektion jedoch bisher verschont.
Bei allen zuvor gemeldeten Fällen wurde das Virus durch Reisende aus dem Ausland in die Schweiz importiert.
Das Bundesamt für Gesundheit (BAG) hält auf seiner offiziellen Internetseite fest, wie prekär die Situation sein dürfte.
Es bestehe in der Schweiz zwar ein grundsätzliches Risiko für eine Dengue-Übertragung. Doch dieses sei «sehr gering und nur unter bestimmten Bedingungen gegeben».
Das wäre etwa folgendes Szenario: «Wenn Mücken das Virus bei einem mit Dengue-Viren infizierten Reiserückkehrer aufnehmen und auf eine andere Person übertragen.»
Ausbreitung ist eine saisonale Frage
Im Schweizerischen Tropen-Institut (TPH) behält man einen kühlen Kopf. Der Biologe Pie Müller gegenüber SRF: «Ich gehe nicht davon aus, dass wir eine konstante Zirkulation von Dengue haben.»
Es sei eine Frage der Saison, da sich Mücken und Viren ab 28 Grad am wohlsten fühlen würden. Wärme beschleunige die Population der Mücken.
«Gleichzeitig können sich die Viren schneller in den Mücken vermehren», so Müller.
Nicht zu vergessen: Der Klimawandel. Die zunehmend ausgedehnten Wärmephasen verlängern laut Experten auch den zeitlichen Rahmen für potenzielle Infektionen.
Prävention beginnt zu Hause
In einem Beitrag von «Telebasel» richtet Parrat einen Appell an die Bevölkerung: «Vermeidet bitte Wasserstellen auf dem Balkon oder im Garten.» Also etwa in Töpfen oder Giesskannen.
Genau dort könnten sich Tigermücken ideal vermehren. Es brauche die Mithilfe von Herrn und Frau Schweizer, um die Mückenpopulation tief zu halten.